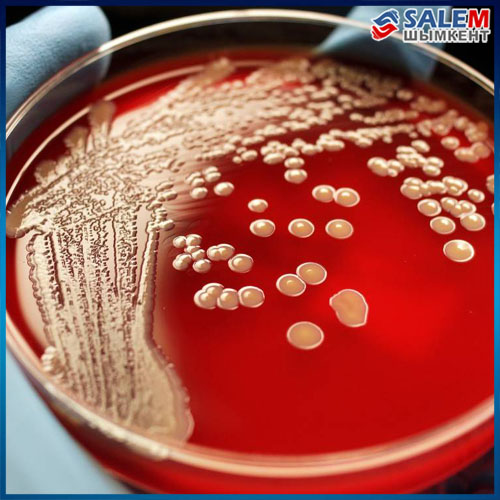

В Шымкенте рассказали о редких именах новорожденных приуроченных к праздникам
Читать статью...Повторное введение карантина может повлечь высвобождение работников и снижение их доходов.
Читать статью...На 1 сентября 2020 года помощь оказана 28,3 тыс. заемщикам на сумму 176,7 млрд тенге, прощена задолженность заемщиков по вознаграждению, штрафам (пени) комиссиям на сумму 123,3 млрд тенге.
Читать статью...Всего в стране подтверждено 107 529 случаев.
Читать статью...Раненого доставили в больницу.
Читать статью...Недавно на том же месте погиб первоклассник.
Читать статью...На западе и юге страны без существенных осадков.
Читать статью...Всего в стране подтверждено 107 450 случаев.
Читать статью...Зараженные разводят и забивают скот. В больницу поступили в состоянии средней тяжести.
Читать статью...На данный момент лечение от коронавирусной инфекции продолжают получать 3 667 человека.
Читать статью...